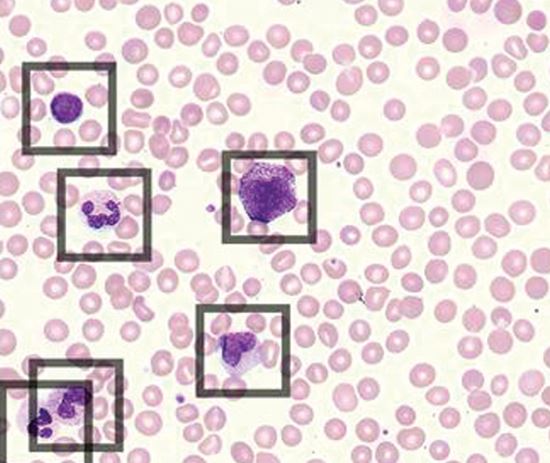

Scopio Labs X100 & X100HT Digital Morphology Solution
The Scopio X100 and X100HT are transforming digital cell morphology analysis with Full-Field Peripheral Blood Smear™ Application and AI-based Decision Support System. This revolutionary technology lets hematology labs zoom, pan and share high-resolution, digitized samples without having to go back to the manual microscope, reducing turnaround time for sample reviews by 60%.1
The Future of Digital Cell Morphology is Now 100X Closer
Imaging tens of thousands of cells at a time, Scopio assists you in diagnosing hematological disorders by transforming the way you look at cells. Detect, pre-classify, and quantify cells for enhanced workflow efficiency and confident clinical decision-making.
AI-based Full-Field Peripheral Blood Smear™ Application
Fields of view for tens of thousands of cells
Reduction in lab review turnaround time 1
Oil immersion resolution
Webinar Full-Field & Fully Digital: The Future of Digital Hematology
Join live webinar on Jan. 30 to hear Robin Johnson lab director at Vista Clinical Diagnostics and and Ahmed Bentahar medical director at Beckman Coulter as they discuss how digital hematology solutions are improving lab performance.
Register hereVideo What’s Hidden at the Edge?
From platelet clumps, malignant cells, and parasitic infections, the full-field view technology of Scopio Labs is helping to provide clinicians more insights, and more answers than the traditional snapshot view.
Watch nowThe Rise of Full-Field Cell Morphology™ and the All-Digital Workflow
Watch Drs. Pozdnyakova and Katz present results from a multi-institutional FDA clinical trial, including representative full-field blood smear scans, simulating comprehensive morphological analysis of real-life blood smears and share experiences using this innovative technology.
See the scan in full context or zoom in on the smallest details all at an unprecedented resolution of 100X.
Workflow Efficiency
With its demonstrated reduction in review time1, AI-driven WBC pre-classification, platelet pre-estimation, and the seamless sharing of results, Scopio is enhancing and improving diagnostic clinical workflows for lab professionals.

Full-Field Digital Imaging
Zoom to simultaneously see the big picture and the tiniest details. Lab review can sign off on a case confidently without reverting to manual microscopy.
Remote Connectivity
Hospital and lab networks: Use remote connectivity to consolidate morphology expertise across all hematology labs in the network with Scopio Network Suite.

Scopio X100 | Scopio X100HT | |||
Throughput |
3-slide tray Up to 15 slides/h for 200 WBC differential |
30-slide capacity (3 cassettes x 10 slides) Up to 40 slides/h for 200 WBC differential |
||
Slide Preparation |
Manual oil drop and coverslip | Automated oil drop and coverslip | ||
Barcode(Slides with no barcodes are alsosupported by the X100 and the X100HT) |
Data matrix Code 128, Code 39, EAN-8, EAN-13, QR Code |
Data matrix Code 128, Code 39, EAN-8, EAN-13, QR Code |
||
Stains |
All Romanowsky stains | All Romanowsky stains | ||
Storage Capacity |
Up to 1.5k scanned samples Up to 15k reports with cell images Up to 100 cases stored indefinitely |
Up to 4.5k scanned samples Up to 45k reports with cell images Up to 200 cases stored indefinitely |
||
X100 Scanner | X100 Processing Unit | X100HT Scanner | X100HT Processing Unit | |
Platform Size (WxDxH) |
14.2 x 12.6 x 14.7 in 36.2 x 32 x 37.5 cm |
12.56 x 6.77 x 14.09 in 31.9 x 17.2 x 35.8 cm |
16.6 x 15.4 x 25.2 in 42 x 39 x 64 cm |
18.2 x 8.6 x 19.1 in 46.3 x 22 x 48.6 cm |
Platform Weight |
29.7 lbs/ 13.5 kg | 18.3 lbs/ 8.3 kg | 65.7 lbs/ 29.8 kg | 37.5 lbs/ 17 kg |
Electrical Specification |
12VDC, 6.67A | 100-240VAC, 47-63Hz, 10-5A |
12V DC, 6.67 A | 100-240VAC, 50-60Hz, 20-l0A |
Download specifications ›
Select Tips & Tools to access helpful documents and information for your instrument.
Step 1: To access content such as job aids, checklists, In-Lab Training Manuals, etc., select the Tips & Tools link in the top left navigation.
Step 2: Select the product name.
Step 3: You will be directed to the product page and access to the product-specific content.
Click here to access Tips & Tools
Scopio Labs
Beckman Coulter is a worldwide distributor of Scopio’s X100 and X100HT next generation peripheral blood smear platforms. We are partnering to add their Full-Field™ Peripheral Blood Smear Application technology to our suite of innovative hematology solutions.
Learn moreAdditional Resources
Hematology Workflow Solutions

DxH 900
Gain confidence in RBC, PLT and WBC differentials through near native-state cellular characterization.

DxH 900 Workcell
Streamline processes with this scalable, customizable hematology workcell solution.

DxH Slidemaker Stainer II
Better results start with better slide making. The SMS II prepares high quality slides to ramp up productivity and quality.

DxH 690T
A smaller footprint to empower clinical decision making and streamline hematology laboratory workflow.
Beckman Coulter is a distributor of Scopio Labs. FDA cleared, CE-marked. Not available in all markets. Please contact your local sales rep for more information about availability.
1. Katz, B. et al. (2021). Evaluation of Scopio Labs X100 Full Field PBS: The first high‐resolution full field viewing of peripheral blood specimens combined with artificial intelligence‐based morphological analysis. International Journal of Laboratory Hematology, 43(6), 1408–1416. https://doi.org/10.1111/ijlh.13681
2. Katz B-Z, Benisty D, Sayegh Y, Lamm I, Avivi I. Remote digital microscopy improves hematology laboratory workflow by reducing peripheral blood smear analysis turnaround time. Appl Clin Inform. Published online October 8, 2022. doi:10.1055/a-1957-6219